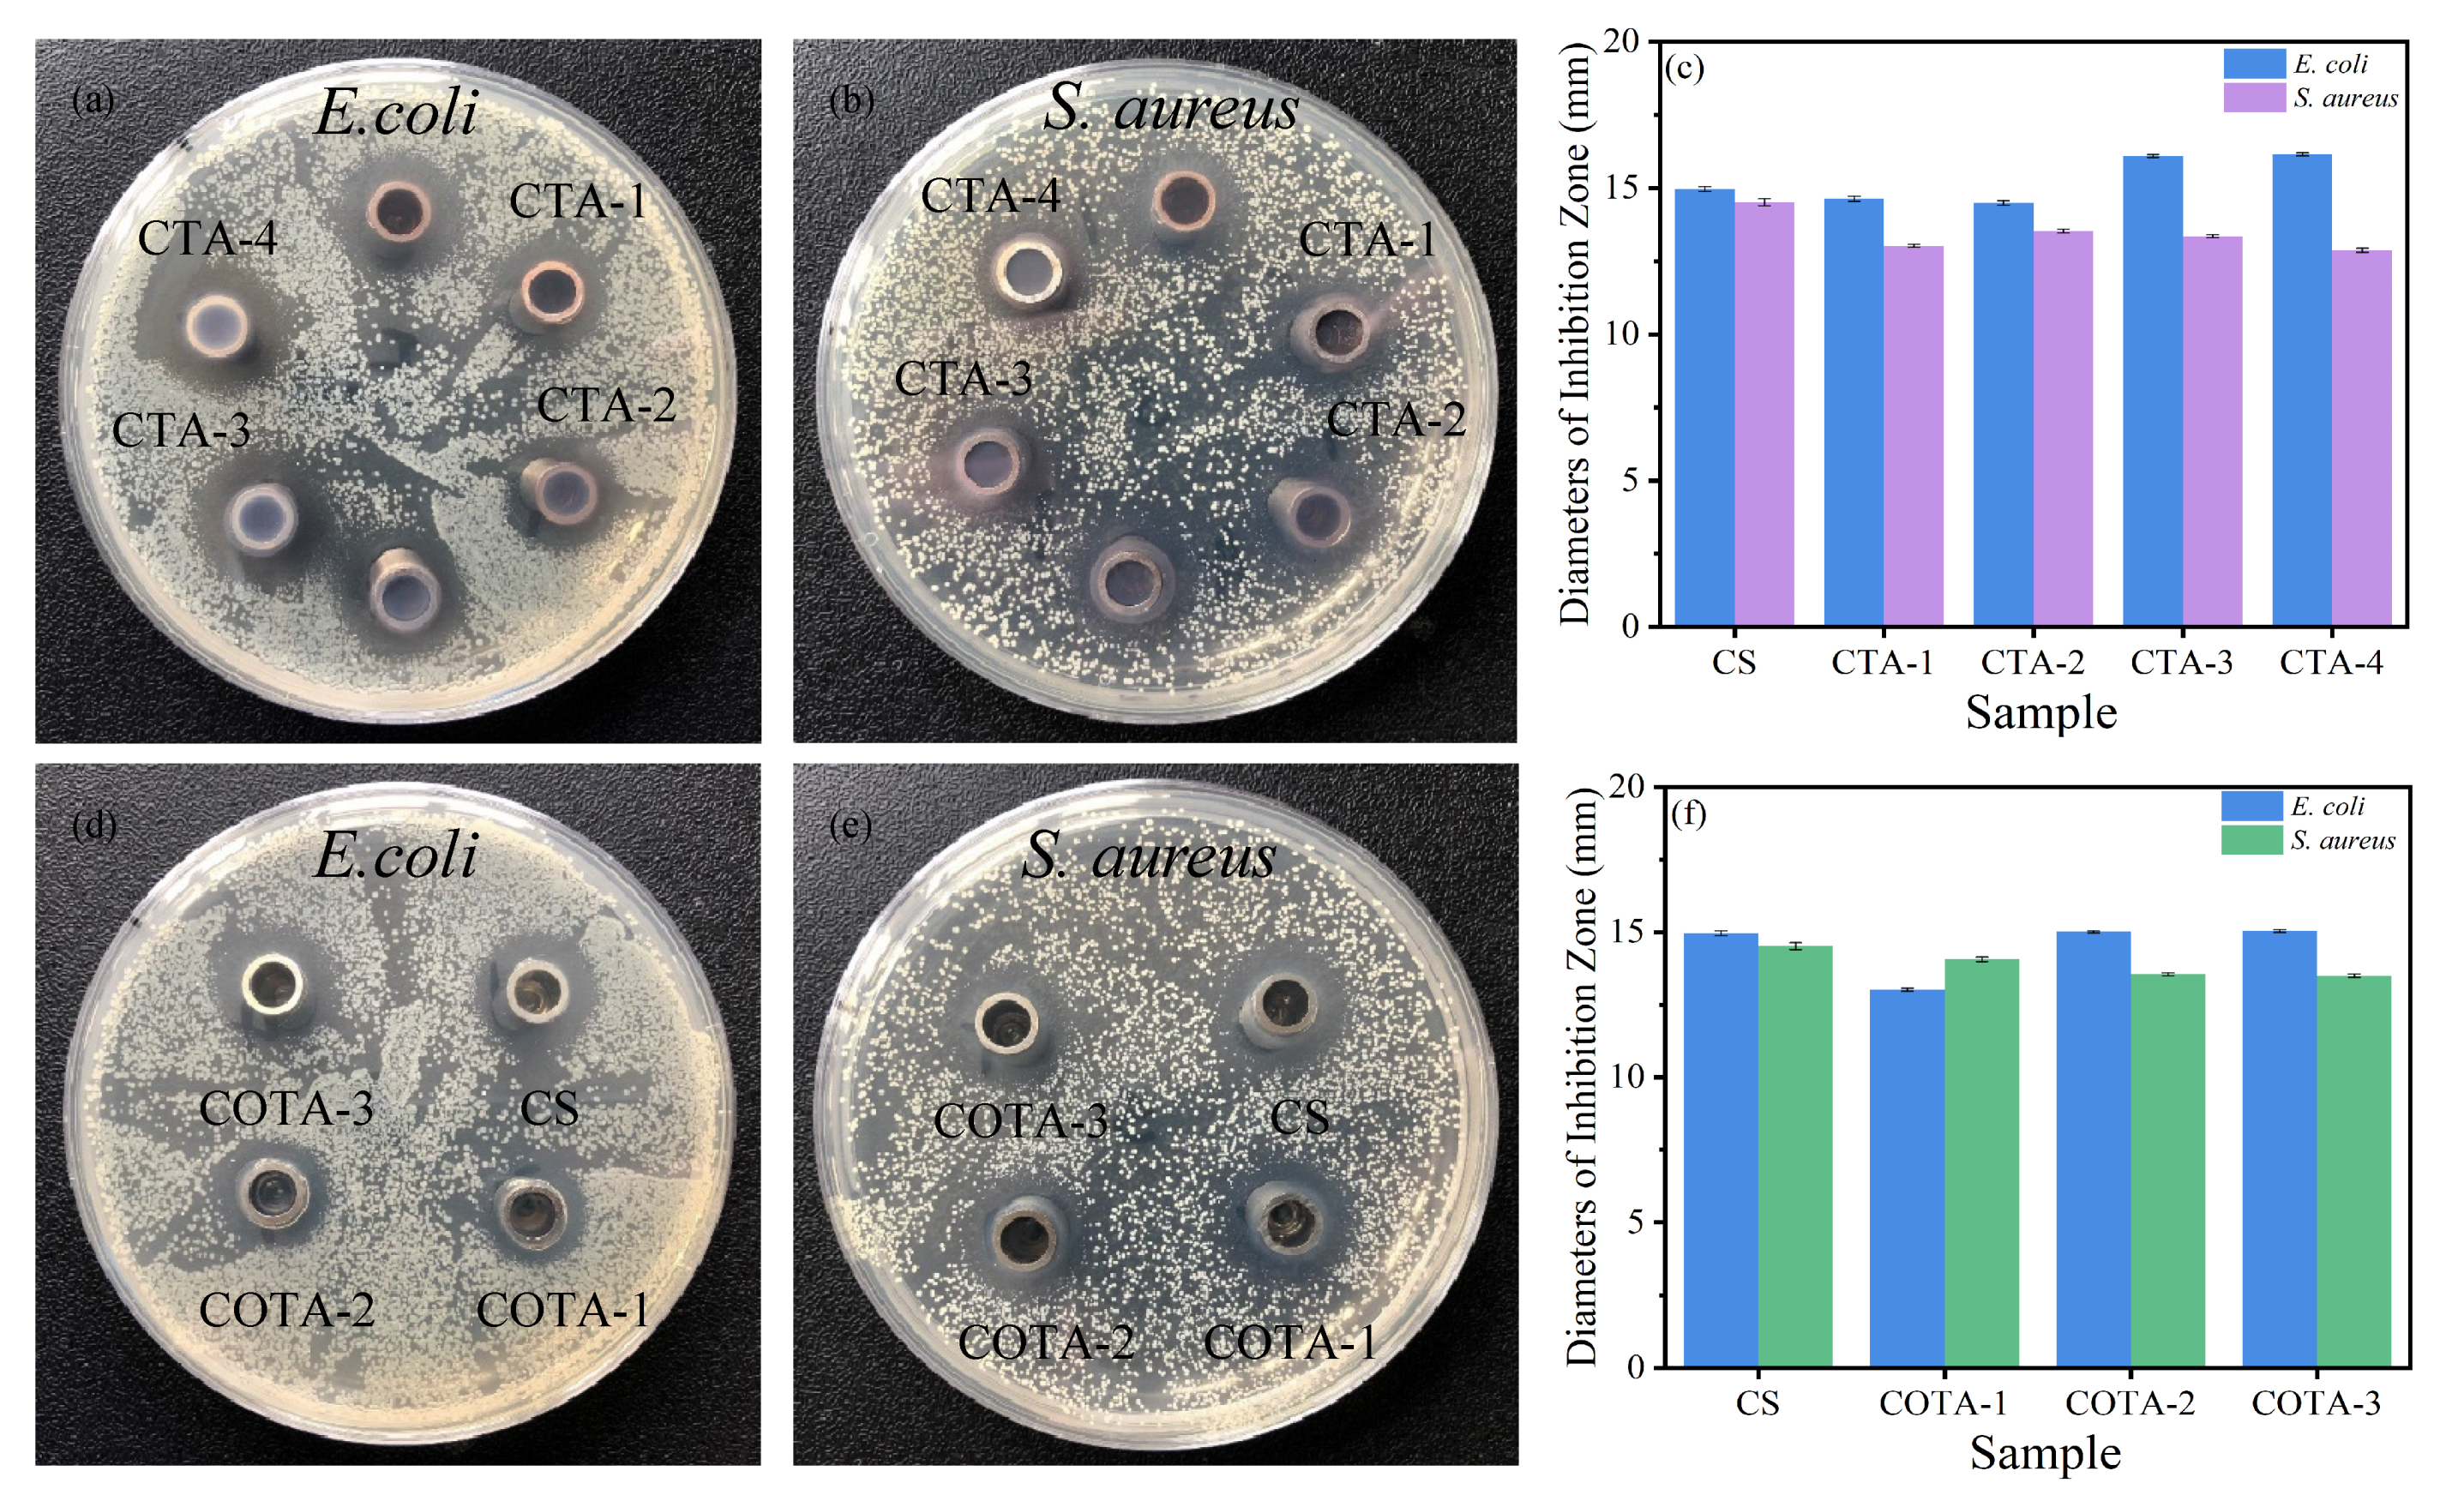
Ijms 23 09284 g011 550

Preparation and Characterization of High Mechanical Strength Chitosan/Oxidized Tannic Acid Composite Film with Schiff Base and Hydrogen Bond Crosslinking
Abstract
:1. Introduction
2. Results and Discussion
2.1. Fourier-Transform Infrared (FTIR) Analysis
2.2. X-ray Diffraction (XRD) Analysis
2.3. X-ray Photoelectron Spectroscopic (XPS) Analysis
2.4. Thermogravimetric Analysis (TGA)
2.5. UV Absorption Spectra, Fluorescence Properties, and Color Aberration Analysis
2.6. Mechanical Properties
2.7. Microstructure Analysis
2.8. Solubility and Water Absorption Analysis
2.9. Analysis of Antibacterial Activity and DPPH Radical Scavenging Rate
3. Materials and Methods
3.1. Materials
3.2. Preparation of OTA
3.3. Preparation of CTA and COTA Composite Films
3.4. Characterization and Testing of Chitosan-Based Composite Film
3.4.1. Fourier-Transform Infrared Spectroscopy (FTIR)
3.4.2. Scanning Electron Microscope (SEM)
3.4.3. Atomic Force Microscopy (AFM)
3.4.4. X-ray Photoelectron Spectroscopy Analysis (XPS)
3.4.5. Thermogravimetric Analysis (TGA)
3.4.6. Mechanical Properties
3.4.7. Ultraviolet–Visible (UV–Vis) Spectroscopy
3.4.8. Fluorescence Spectrometer Analysis
3.4.9. Antibacterial Properties
3.4.10. Water Solubility and Water Absorption
3.4.11. Color Aberration Analysis
3.4.12. Scavenging Rate of the DPPH Radical
4. Conclusions
Author Contributions
Funding
Institutional Review Board Statement
Data Availability Statement
Acknowledgments
Conflicts of Interest
References
- Measham, T.G.; Fleming, D.A.; Schandl, H. A conceptual model of the socioeconomic impacts of unconventional fossil fuel extraction. Glob. Environ. Change-Hum. Policy Dimens. 2016, 36, 101–110. [Google Scholar] [CrossRef]
- Guzel Kaya, G.; Aznar, E.; Deveci, H.; Martinez-Manez, R. Aerogels as promising materials for antibacterial applications: A mini-review. Biomater. Sci. 2021, 9, 7034–7048. [Google Scholar] [CrossRef] [PubMed]
- Ren, J.; Wang, Y.; Yao, Y.; Wang, Y.; Fei, X.; Qi, P.; Lin, S.; Kaplan, D.L.; Buehler, M.J.; Ling, S. Biological Material Interfaces as Inspiration for Mechanical and Optical Material Designs. Chem. Rev. 2019, 119, 12279–12336. [Google Scholar] [CrossRef] [PubMed]
- Muzzarelli, R.A.; Biagini, G.; Bellardini, M.; Simonelli, L.; Castaldini, C.; Fratto, G. Osteoconduction exerted by methylpyrrolidinone chitosan used in dental surgery. Biomaterials 1993, 14, 39–43. [Google Scholar] [CrossRef]
- Bailey, S.E.; Olin, T.J.; Bricka, R.M.; Adrian, D.D. A review of potentially low-cost sorbents for heavy metals. Water Res. 1999, 33, 2469–2479. [Google Scholar] [CrossRef]
- Vicentini, D.S.; Smania, A., Jr.; Laranjeira, M.C.M. Chitosan/poly (vinyl alcohol) films containing ZnO nanoparticles and plasticizers. Mater. Sci. Eng. C-Mater. Biol. Appl. 2010, 30, 503–508. [Google Scholar] [CrossRef]
- Varma, A.J.; Deshpande, S.V.; Kennedy, J.F. Metal complexation by chitosan and its derivatives: A review. Carbohydr. Polym. 2004, 55, 77–93. [Google Scholar] [CrossRef]
- Wu, D.; Zhou, J.; Creyer, M.N.; Yim, W.; Chen, Z.; Messersmith, P.B.; Jokerst, J.V. Phenolic-enabled nanotechnology: Versatile particle engineering for biomedicine. Chem. Soc. Rev. 2021, 50, 4432–4483. [Google Scholar] [CrossRef]
- Jin, Y.-N.; Yang, H.-C.; Huang, H.; Xu, Z.-K. Underwater superoleophobic coatings fabricated from tannic acid-decorated carbon nanotubes. RSC Adv. 2015, 5, 16112–16115. [Google Scholar] [CrossRef]
- Liang, H.; Zhou, B.; Wu, D.; Li, J.; Li, B. Supramolecular design and applications of polyphenol-based architecture: A review. Adv. Colloid Interface Sci. 2019, 272, 102019. [Google Scholar] [CrossRef]
- Sakihama, Y.; Cohen, M.F.; Grace, S.C.; Yamasaki, H. Plant phenolic antioxidant and prooxidant activities: Phenolics-induced oxidative damage mediated by metals in plants. Toxicology 2002, 177, 67–80. [Google Scholar] [CrossRef]
- Wang, Z.; Zhao, S.; Kang, H.; Zhang, W.; Zhang, S.; Li, J. Mussel byssus-inspired engineering of synergistic nanointerfacial interactions as sacrificial bonds into carbon nanotube-reinforced soy protein/nanofibrillated cellulose nanocomposites:Versatile mechanical enhancement. Appl. Surf. Sci. 2018, 434, 1086–1100. [Google Scholar] [CrossRef]
- Kloucek, P.; Polesny, Z.; Svobodova, B.; Vlkova, E.; Kokoska, L. Antibacterial screening of some Peruvian medicinal plants used in Calleria District. J. Ethnopharmacol. 2005, 99, 309–312. [Google Scholar] [CrossRef]
- Guo, Z.H.; Xie, W.S.; Lu, J.S.; Guo, X.X.; Xu, J.Z.; Xu, W.L.; Chi, Y.J.; Takuya, N.; Wu, H.; Zhao, L.Y. Tannic acid-based metal phenolic networks for bio-applications: A review. J. Mat. Chem. B 2021, 9, 4098–4110. [Google Scholar] [CrossRef] [PubMed]
- Kumar, N.; Goel, N. Phenolic acids: Natural versatile molecules with promising therapeutic applications. Biotechnol. Rep. 2019, 24, e00370. [Google Scholar] [CrossRef] [PubMed]
- Bigham, A.; Rahimkhoei, V.; Abasian, P.; Delfi, M.; Naderi, J.; Ghomi, M.; Dabbagh Moghaddam, F.; Waqar, T.; Nuri Ertas, Y.; Sharifi, S.; et al. Advances in tannic acid-incorporated biomaterials: Infection treatment, regenerative medicine, cancer therapy, and biosensing. Chem. Eng. J. 2022, 432, 134146. [Google Scholar] [CrossRef]
- Guo, J.; Suma, T.; Richardson, J.J.; Ejima, H. Modular Assembly of Biomaterials Using Polyphenols as Building Blocks. ACS Biomater. Sci. Eng. 2019, 5, 5578–5596. [Google Scholar] [CrossRef]
- Taheri, P.; Jahanmardi, R.; Koosha, M.; Abdi, S. Physical, mechanical and wound healing properties of chitosan/gelatin blend films containing tannic acid and/or bacterial nanocellulose. Int. J. Biol. Macromol. 2020, 154, 421–432. [Google Scholar] [CrossRef]
- Zhang, C.C.; Yang, Z.K.; Shi, J.Y.; Zou, X.B.; Zhai, X.D.; Huang, X.W.; Li, Z.H.; Holmes, M.; Daglia, M.; Xiao, J.B. Physical properties and bioactivities of chitosan/gelatin-based films loaded with tannic acid and its application on the preservation of fresh-cut apples. LWT-Food Sci. Technol. 2021, 144, 9. [Google Scholar] [CrossRef]
- Aewsiri, T.; Benjakul, S.; Visessanguan, W.; Wierenga, P.A.; Gruppen, H. Antioxidative activity and emulsifying properties of cuttlefish skin gelatin-tannic acid complex as influenced by types of interaction. Innov. Food Sci. Emerg. Technol. 2010, 11, 712–720. [Google Scholar] [CrossRef]
- Loi, M.; Quintieri, L.; Fanelli, F.; Caputo, L.; Mule, G. Application of a recombinant laccase-chlorogenic acid system in protein crosslink and antioxidant properties of the curd. Food Res. Int. 2018, 106, 763–770. [Google Scholar] [CrossRef]
- Ryu, S.H.; Lee, A.Y.; Kim, M. Molecular characteristics of two laccase from the basidiomycete fungus Polyporus brumalis. J. Microbiol. 2008, 46, 62–69. [Google Scholar] [CrossRef] [PubMed]
- Afreen, S.; Anwer, R.; Singh, R.K.; Fatma, T. Extracellular laccase production and its optimization from Arthrospira maxima catalyzed decolorization of synthetic dyes. Saudi J. Biol. Sci. 2018, 25, 1446–1453. [Google Scholar] [CrossRef] [PubMed]
- Hernandez-Monjaraz, W.S.; Caudillo-Perez, C.; Salazar-Sanchez, P.U.; Macias-Sanchez, K.L. Influence of iron and copper on the activity of laccases in Fusarium oxysporum f. sp. lycopersici. Braz. J. Microbiol. 2018, 49, 269–275. [Google Scholar] [CrossRef] [PubMed]
- Galli, C.; Madzak, C.; Vadala, R.; Jolivalt, C.; Gentili, P. Concerted Electron/ Proton Transfer Mechanism in the Oxidation of Phenols by Laccase. ChemBioChem 2013, 14, 2500–2505. [Google Scholar] [CrossRef]
- Mate, D.M.; Alcalde, M. Laccase engineering: From rational design to directed evolution. Biotechnol. Adv. 2015, 33, 25–40. [Google Scholar] [CrossRef]
- Kudanga, T.; Nemadziva, B.; Le Roes-Hill, M. Laccase catalysis for the synthesis of bioactive compounds. Appl. Microbiol. Biotechnol. 2017, 101, 13–33. [Google Scholar] [CrossRef]
- Das, R.; Liang, Z.S.; Li, G.Y.; An, T.C. A non-blue laccase of Bacillus sp. GZB displays manganese-oxidase activity: A study of laccase characterization, Mn(II) oxidation and prediction of Mn(II) oxidation mechanism. Chemosphere 2020, 252, 11. [Google Scholar] [CrossRef]
- Avanthi, A.; Banerjee, R. A strategic laccase mediated lignin degradation of lignocellulosic feedstocks for ethanol production. Ind. Crop. Prod. 2016, 92, 174–185. [Google Scholar] [CrossRef]
- Bozic, M.; Gorgieva, S.; Kokol, V. Laccase-mediated functionalization of chitosan by caffeic and gallic acids for modulating antioxidant and antimicrobial properties. Carbohydr. Polym. 2012, 87, 2388–2398. [Google Scholar] [CrossRef]
- Bersanetti, P.A.; Escobar, V.H.; Nogueira, R.F.; Ortega, F.D.; Schor, P.; Morandim-Giannetti, A.D. Enzymatically obtaining hydrogels of PVA crosslinked with ferulic acid in the presence of laccase for biomedical applications. Eur. Polym. J. 2019, 112, 610–618. [Google Scholar] [CrossRef]
- Muzzarelli, R.A.A.; Littarrua, G.; Muzzarelli, C.; Tosi, G. Selective reactivity of biochemically relevant quinones towards chitosans. Carbohydr. Polym. 2003, 53, 109–115. [Google Scholar] [CrossRef]
- Desentis-Mendoza, R.M.; Hernandez-Sanchez, H.; Moreno, A.; Emilio, R.D.C.; Chel-Guerrero, L.; Tamariz, J.; Jaramillo-Flores, M.E. Enzymatic polymerization of phenolic compounds using laccase and tyrosinase from Ustilago maydis. Biomacromolecules 2006, 7, 1845–1854. [Google Scholar] [CrossRef]
- Zhang, Q.; Qiao, Y.S.; Li, C.J.; Lin, J.; Han, H.; Li, X.L.; Mao, J.F.; Wang, F.J.; Wang, L. Chitosan/gelatin-tannic acid decorated porous tape suture with multifunctionality for tendon healing. Carbohydr. Polym. 2021, 268, 12. [Google Scholar] [CrossRef] [PubMed]
- Matet, M.; Heuzey, M.C.; Pollet, E.; Ajji, A.; Averous, L. Innovative thermoplastic chitosan obtained by thermo-mechanical mixing with polyol plasticizers. Carbohydr. Polym. 2013, 95, 241–251. [Google Scholar] [CrossRef] [PubMed]
- Kittur, F.S.; Kumar, A.B.V.; Tharanathan, R.N. Low molecular weight chitosans—Preparation by depolymerization with Aspergillus niger pectinase, and characterization. Carbohydr. Res. 2003, 338, 1283–1290. [Google Scholar] [CrossRef]
- Yan, Y.T.; Wang, K.L.; Wang, Z.; Gindl-Altmutter, W.; Zhang, S.F.; Li, J.Z. Fabrication of homogeneous and enhanced soybean protein isolate-based composite films via incorporating TEMPO oxidized nanofibrillated cellulose stablized nano-ZnO hybrid. Cellulose 2017, 24, 4807–4819. [Google Scholar] [CrossRef]
- Rhim, J.W.; Hong, S.I.; Park, H.M.; Ng, P.K.W. Preparation and characterization of chitosan-based nanocomposite films with antimicrobial activity. J. Agric. Food Chem. 2006, 54, 5814–5822. [Google Scholar] [CrossRef]
- Ulu, A.; Birhanli, E.; Ates, B. Tunable and tough porous chitosan/beta-cyclodextrin/tannic acid biocomposite membrane with mechanic, antioxidant, and antimicrobial properties. Int. J. Biol. Macromol. 2021, 188, 696–707. [Google Scholar] [CrossRef]
- Zhao, S.S.; Jia, R.Y.; Yang, J.; Dai, L.; Ji, N.; Xiong, L.; Sun, Q.J. Development of chitosan/tannic acid/corn starch multifunctional bilayer smart films as pH-responsive actuators and for fruit preservation. Int. J. Biol. Macromol. 2022, 205, 419–429. [Google Scholar] [CrossRef]
- Dong, Z.Z.; Cui, H.R.; Wang, Y.D.; Wang, C.L.; Li, Y.; Wang, C.Q. Biocompatible AIE material from natural resources: Chitosan and its multifunctional applications. Carbohydr. Polym. 2020, 227, 9. [Google Scholar] [CrossRef] [PubMed]
- Ojagh, S.M.; Rezaei, M.; Razavi, S.H.; Hosseini, S.M.H. Development and evaluation of a novel biodegradable film made from chitosan and cinnamon essential oil with low affinity toward water. Food Chem. 2010, 122, 161–166. [Google Scholar] [CrossRef]
- Park, P.J.; Je, J.Y.; Kim, S.K. Free radical scavenging activities of differently deacetylated chitosans using an ESR spectrometer. Carbohydr. Polym. 2004, 55, 17–22. [Google Scholar] [CrossRef]
- Ge, W.J.; Cao, S.; Shen, F.; Wang, Y.Y.; Ren, J.L.; Wang, X.H. Rapid self-healing, stretchable, moldable, antioxidant and antibacterial tannic acid-cellulose nanofibril composite hydrogels. Carbohydr. Polym. 2019, 224, 9. [Google Scholar] [CrossRef]
- Bi, F.Y.; Zhang, X.; Bai, R.Y.; Liu, Y.P.; Liu, J.; Liu, J. Preparation and characterization of antioxidant and antimicrobial packaging films based on chitosan and proanthocyanidins. Int. J. Biol. Macromol. 2019, 134, 11–19. [Google Scholar] [CrossRef] [PubMed]
- Xu, F.J.; Dong, Y.M.; Zhang, W.; Zhang, S.F.; Li, L.; Li, J.Z. Preparation of cross-linked soy protein isolate-based environmentally-friendly films enhanced by PTGE and PAM. Ind. Crops Prod. 2015, 67, 373–380. [Google Scholar] [CrossRef]

| Samples | Tmax (°C) * | Residue at 600 °C (%) |
|---|---|---|
| CS | 284.0 | 38.98 |
| CTA-1 | 283.6 | 39.62 |
| CTA-2 | 283.1 | 40.59 |
| CTA-3 | 282.8 | 40.13 |
| CTA-4 | 282.4 | 42.01 |
| COTA-1 | 281.8 | 36.98 |
| COTA-2 | 280.9 | 36.59 |
| COTA-3 | 281.4 | 35.62 |
| Samples | L* | a* | b* | ∆E* |
|---|---|---|---|---|
| CS | 41.35 | 1.82 | 8.66 | 0.09 |
| CTA-1 | 26.89 | 13.60 | 6.73 | 18.77 |
| CTA-2 | 24.06 | 18.15 | 7.19 | 23.85 |
| CTA-3 | 23.43 | 19.93 | 9.18 | 25.50 |
| CTA-4 | 20.74 | 22.40 | 8.57 | 29.15 |
| COTA-1 | 35.09 | 5.04 | 6.39 | 7.42 |
| COTA-2 | 33.26 | 7.21 | 6.28 | 10.04 |
| COTA-3 | 32.74 | 8.42 | 4.01 | 11.85 |
| Samples | Tensile Strength (MPa) | Elongation at Break (%) | Tenacity (MJ/m3) | Young’s Modulus (MPa) |
|---|---|---|---|---|
| CS | 42.6 ± 1.2 | 23.8 ± 1.2 | 8.6 ± 0.7 | 1991.3 ± 65.8 |
| CTA-1 | 54.6 ± 0.3 | 18.5 ± 0.4 | 8.6 ± 0.3 | 2620.3 ± 28.6 |
| CTA-2 | 58.8 ± 1.4 | 16.6 ± 0.8 | 8.5 ± 0.6 | 3040.9 ± 78.9 |
| CTA-3 | 73.5 ± 3.5 | 5.8 ± 0.3 | 3.2 ± 0.2 | 3385.5 ± 96.5 |
| CTA-4 | 80.7 ± 2.8 | 5.6 ± 0.5 | 2.7 ± 0.4 | 3497.4 ± 99.9 |
| COTA-1 | 68.4 ± 1.2 | 6.5 ± 0.9 | 3.4 ± 0.3 | 3352.8 ± 52.3 |
| COTA-2 | 72.4 ± 0.5 | 8.9 ± 0.9 | 5.3 ± 0.4 | 3836.8 ± 72.4 |
| COTA-3 | 84.0 ± 0.8 | 6.4 ± 0.6 | 4.2 ± 0.3 | 4241.7 ± 98.3 |
| Samples | Sq (nm) | Sa (nm) | Sz (nm) | Ssk |
|---|---|---|---|---|
| CS | 11.7 | 9.1 | 102.4 | 0.5245 |
| CTA-2 | 22 | 16.4 | 211.7 | 1.0959 |
| COTA-1 | 11.9 | 9.4 | 94.8 | 0.4261 |
| Samples | Thickness (mm) | Water Content (%) | Water Absorption (%) | Solubility (%) |
|---|---|---|---|---|
| CS | 0.111 ± 0.002 | 16.84 ± 0.02 | 62.18 ± 0.05 | 18.31 ± 0.02 |
| CTA-1 | 0.135 ± 0.005 | 16.20 ± 0.04 | 71.81 ± 0.07 | 20.56 ± 0.05 |
| CTA-2 | 0.165 ± 0.004 | 15.13 ± 0.05 | 72.88 ± 0.03 | 20.53 ± 0.06 |
| CTA-3 | 0.187 ± 0.005 | 14.76 ± 0.03 | 66.93 ± 0.08 | 19.31 ± 0.05 |
| CTA-4 | 0.191 ± 0.003 | 14.22 ± 0.04 | 64.32 ± 0.09 | 14.78 ± 0.07 |
| COTA-1 | 0.155 ± 0.003 | 15.06 ± 0.04 | 73.33 ± 0.08 | 17.53 ± 0.03 |
| COTA-2 | 0.165 ± 0.002 | 16.75 ± 0.03 | 72.61 ± 0.05 | 10.00 ± 0.05 |
| COTA-3 | 0.160 ± 0.005 | 16.59 ± 0.05 | 71.07 ± 0.06 | 10.32 ± 0.02 |
| Samples | Chitosan (g) | Tannic Acid (g) (%) * | Oxidized Tannic Acid (g) (%) ** |
|---|---|---|---|
| CS | 1.0 | – | – |
| CTA-1 | 1.0 | 0.05 (5%) | – |
| CTA-2 | 1.0 | 0.10 (10%) | – |
| CTA-3 | 1.0 | 0.15 (15%) | – |
| CTA-4 | 1.0 | 0.20 (20%) | – |
| COTA-1 | 1.0 | – | 0.01 (1%) |
| COTA-2 | 1.0 | – | 0.02 (2%) |
| COTA-3 | 1.0 | – | 0.03 (3%) |
Publisher’s Note: MDPI stays neutral with regard to jurisdictional claims in published maps and institutional affiliations. |
© 2022 by the authors. Licensee MDPI, Basel, Switzerland. This article is an open access article distributed under the terms and conditions of the Creative Commons Attribution (CC BY) license (https://creativecommons.org/licenses/by/4.0/).
Share and Cite
Qin, Z.; Huang, Y.; Xiao, S.; Zhang, H.; Lu, Y.; Xu, K. Preparation and Characterization of High Mechanical Strength Chitosan/Oxidized Tannic Acid Composite Film with Schiff Base and Hydrogen Bond Crosslinking. Int. J. Mol. Sci. 2022, 23, 9284. https://doi.org/10.3390/ijms23169284
Qin Z, Huang Y, Xiao S, Zhang H, Lu Y, Xu K. Preparation and Characterization of High Mechanical Strength Chitosan/Oxidized Tannic Acid Composite Film with Schiff Base and Hydrogen Bond Crosslinking. International Journal of Molecular Sciences. 2022; 23(16):9284. https://doi.org/10.3390/ijms23169284
Chicago/Turabian StyleQin, Zhiyong, Youjia Huang, Siyu Xiao, Haoyu Zhang, Yunlong Lu, and Kaijie Xu. 2022. "Preparation and Characterization of High Mechanical Strength Chitosan/Oxidized Tannic Acid Composite Film with Schiff Base and Hydrogen Bond Crosslinking" International Journal of Molecular Sciences 23, no. 16: 9284. https://doi.org/10.3390/ijms23169284
APA StyleQin, Z., Huang, Y., Xiao, S., Zhang, H., Lu, Y., & Xu, K. (2022). Preparation and Characterization of High Mechanical Strength Chitosan/Oxidized Tannic Acid Composite Film with Schiff Base and Hydrogen Bond Crosslinking. International Journal of Molecular Sciences, 23(16), 9284. https://doi.org/10.3390/ijms23169284

